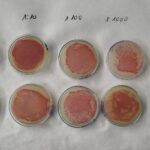
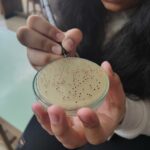

Dins l’assignatura de Tècniques de Laboratori de 2n de BatxiPRO, aquesta setmana hem realitzar una pràctica fonamental en microbiologia: el cultiu i recompte de bacteris.
L’objectiu principal de la sessió ha estat determinar la concentració de microorganismes presents en un medi líquid. Per aconseguir un recompte fiable, els alumnes han fet un banc de dilucions seriades. Aquest procediment permet reduir la concentració de la mostra original de manera esglaonada per obtenir plaques amb un nombre de colònies comptable.
Posteriorment, s’ha realitzat la sembra en plaques de Petri utilitzant un medi de cultiu adequat. Després del període d’incubació, els resultats han estat molt visuals i clars. Mitjançant el recompte de les Unitats Formadores de Colònies (UFC), l’alumnat ha aplicat els càlculs matemàtics necessaris per determinar la càrrega microbiana original.
El resultat final obtingut ha estat d’una concentració de 2,7 milions de microorganismes per ml, demostrant l’eficàcia de la tècnica i la precisió del treball realitzat pels estudiants al laboratori.